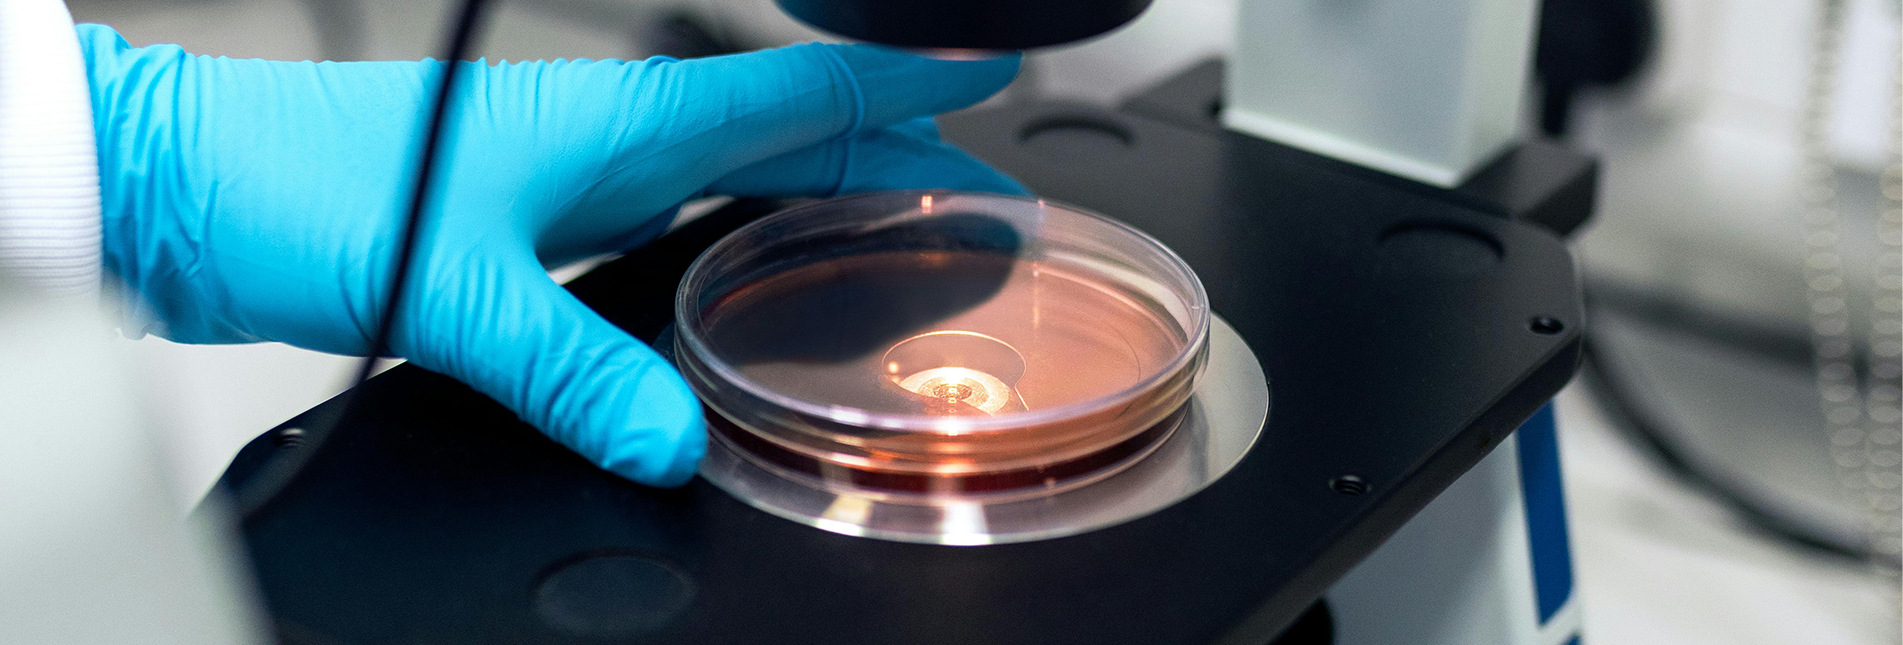

立即搜索
立即搜索
科研全覆蓋檢測
媒體中心


四川里來思諾生物科技有限公司承諾書
2023-11-10
MORE+

四川里來思諾生物科技有限公司關(guān)于遵守法定要求、獨(dú)立公正從業(yè)、履行社會責(zé)任、嚴(yán)守誠實(shí)信用的自我承諾
2023-11-10
MORE+

凝聚鄉(xiāng)情勇?lián)鐣?zé)任,同心共筑助力鄉(xiāng)村振興
2025-12-01
MORE+

里來思諾邀您共赴蘇州 | SAPA-China 2025 醫(yī)藥產(chǎn)業(yè)大會參展預(yù)告
2025-10-29
MORE+

里來“湘”邀 共赴盛會 | 中國醫(yī)學(xué)裝備協(xié)會病理裝備分會第九屆學(xué)術(shù)年會
2025-10-16
MORE+

盛況回顧 | 里來思諾深度參與第三屆全國醫(yī)療器械實(shí)驗(yàn)病理學(xué)暨高端醫(yī)療器械創(chuàng)新大會
2025-05-15
MORE+

2024-02-25
里來思諾 | 邀您參加第七屆AntibodyChina 2024千人峰會!
MORE +

四川里來思諾生物科技有限公司承諾書
MORE+

四川里來思諾生物科技有限公司關(guān)于遵守法定要求、獨(dú)立公正從業(yè)、履行社會責(zé)任、嚴(yán)守誠實(shí)信用的自我承諾
MORE+

凝聚鄉(xiāng)情勇?lián)鐣?zé)任,同心共筑助力鄉(xiāng)村振興
MORE+

里來思諾邀您共赴蘇州 | SAPA-China 2025 醫(yī)藥產(chǎn)業(yè)大會參展預(yù)告
MORE+

里來“湘”邀 共赴盛會 | 中國醫(yī)學(xué)裝備協(xié)會病理裝備分會第九屆學(xué)術(shù)年會
MORE+

盛況回顧 | 里來思諾深度參與第三屆全國醫(yī)療器械實(shí)驗(yàn)病理學(xué)暨高端醫(yī)療器械創(chuàng)新大會
MORE+
加載更多




號二維碼.jpg)


